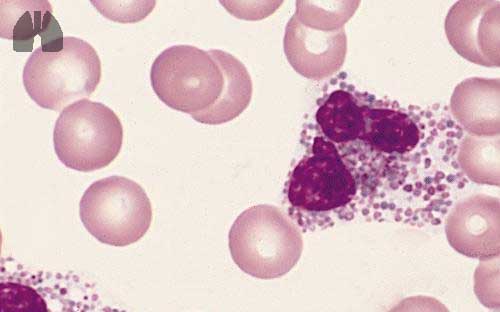

in a large subset of patients with asthma, blood eosinophilia is common, as a marker of T helper 2 cell (Th2) inflammation. Hypereosinophilia (HE), defined by blood eosinophil count >1500/mm3, is rare, observed in 0.3% of asthmatic patients . Classically, in the context of uncontrolled asthma and HE, allergic bronchopulmonary aspergillosis, vasculitis or parasitic infection must be investigated . Asthma is also a feature of HE related to various haematological disorders, although respiratory manifestations are rarely isolated in this setting .
Footnotes
This manuscript has recently been accepted for publication in the European Respiratory Journal. It is published here in its accepted form prior to copyediting and typesetting by our production team. After these production processes are complete and the authors have approved the resulting proofs, the article will move to the latest issue of the ERJ online. Please open or download the PDF to view this article.
Conflict of interest: Dr. Tabeze has nothing to disclose.
Conflict of interest: Dr. Marchand-Adam has nothing to disclose.
Conflict of interest: Dr. BORIE reports grants and personal fees from Boerhinger ingelheim, grants and personal fees from Roche, outside the submitted work.
Conflict of interest: Dr. JUSTET has nothing to disclose.
Conflict of interest: Dr. DOMBRET has nothing to disclose.
Conflict of interest: Dr. CRESTANI reports grants and personal fees from Boerhinger ingelheim, grants and personal fees from Roche, grants from Apellis, personal fees from Astra Zeneca, grants from Medimmune, personal fees from Sanofi, outside the submitted work.
Conflict of interest: Dr. TAILLE reports personal fees and other from Astra Zeneca, personal fees and other from Boeringher, personal fees from Chiesi, grants, personal fees and other from GSK, personal fees and other from Novartis, personal fees from Teva, personal fees and other from ALK, other from Sanofi, outside the submitted work.
Conflict of interest: Dr. Dupin has nothing to disclose.